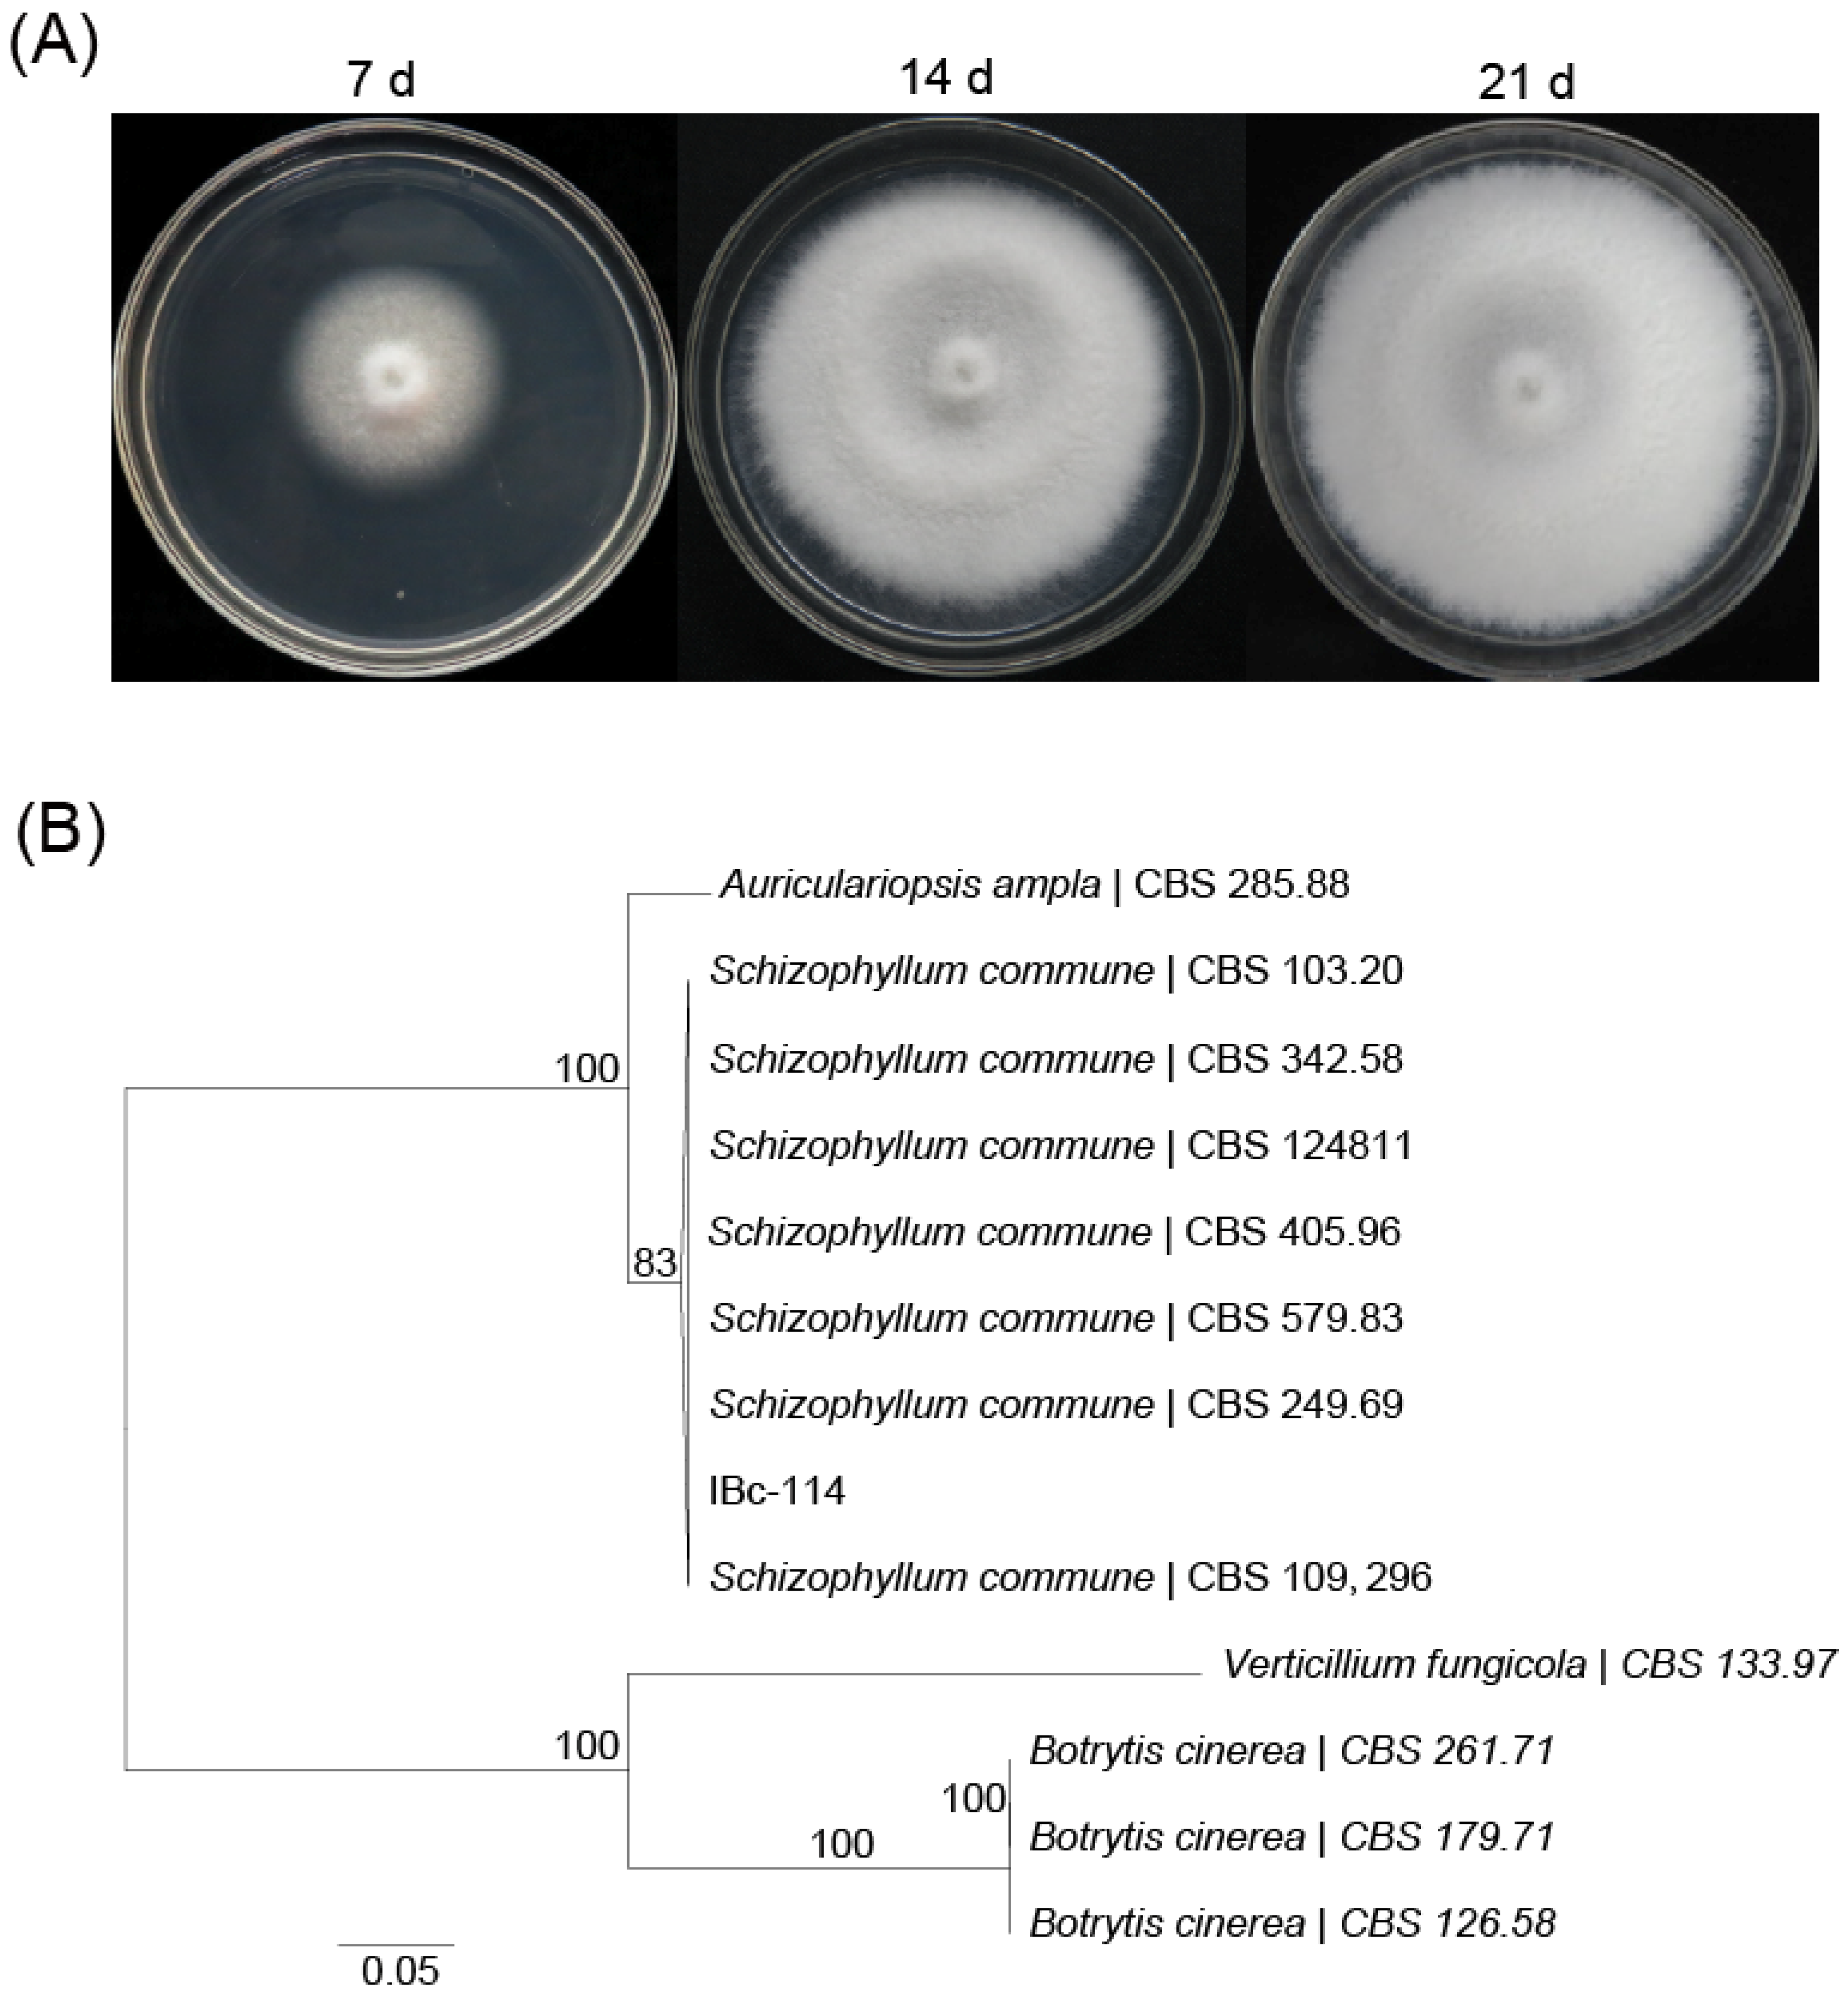
Viruses 16 01767 g001

A Mycovirus Representing a Novel Lineage and a Mitovirus of Botrytis cinerea Co-Infect a Basidiomycetous Fungus, Schizophyllum commune
Abstract
1. Introduction
2. Materials and Methods
2.1. Fungal Isolates and Culture Conditions
2.2. Identification of Strain IBc-114
2.3. Total RNA and dsRNA Extraction, Sequencing and Detection of Mycoviruses in Strain IBc-114
2.4. Cloning of Full-Length Genome Sequence of Mycoviruses
2.5. Analysis of Mycoviral Genome Sequences
2.6. Virus Particle Extraction and Observation
2.7. 4D-FastDIA-Based Proteomic of Proteins in 40% Sucrose Solution
2.8. Protoplast Preparation and Biological Characteristics of Virus-Infected Strains
2.9. Transfection with the Viral RNAs
2.10. Phenotypic Characteristics and Virulence Assay of Transfectants
2.11. Viral Horizontal Transmission and Detection of Mycoviruses by RT-PCR
2.12. Data Analyses
2.13. Viral and Nucleotide Sequence Accession Numbers
3. Results
3.1. Identification of Strain IBc-114 as Schizophyllum commune
3.2. Identification of Two Mycoviruses in Strain IBc-114
3.3. Schizophyllum commune RNA Virus 1 (ScRV1)
3.3.1. Complete Sequence and Organization of ScRV1 Genome
3.3.2. Purification of Viral Particles from Strain IBc-114
3.3.3. Phylogenetic Analysis of ScRV1
3.4. Genome of Botrytis cinerea Mitovirus 9 Strain IBc-114 (BcMV9/IBc-114)
3.5. The Impact of Viruses ScRV1 and BcMV9/IBc-114 on the Host
3.6. Horizontal Transmission of ScRV1 and BcMV9/IBc-114
3.7. BcMV9/IBc-114 Can Successfully Infect B. cinerea and S. sclerotiorum
4. Discussion
Supplementary Materials
Author Contributions
Funding
Institutional Review Board Statement
Informed Consent Statement
Data Availability Statement
Acknowledgments
Conflicts of Interest
References
- Ghabrial, S.A.; Suzuki, N. Viruses of plant pathogenic fungi. Annu. Rev. Phytopathol. 2009, 47, 353–384. [Google Scholar] [CrossRef] [PubMed]
- Ghabrial, S.A.; Castón, J.R.; Jiang, D.; Nibert, M.L.; Suzuki, N. 50-plus years of fungal viruses. Virology 2015, 479, 356–368. [Google Scholar] [CrossRef] [PubMed]
- Kondo, H.; Botella, L.; Suzuki, N. Mycovirus diversity and evolution revealed/inferred from recent studies. Annu. Rev. Phytopathol. 2022, 60, 307–336. [Google Scholar] [CrossRef]
- Myers, J.M.; James, T.Y. Mycoviruses. Curr. Biol. 2022, 32, R150–R155. [Google Scholar] [CrossRef]
- Kotta-Loizou, I. Mycoviruses and their role in fungal pathogenesis. Curr. Opin. Microbiol. 2021, 63, 10–18. [Google Scholar] [CrossRef]
- Xie, J.; Jiang, D. New insights into mycoviruses and exploration for the biological control of crop fungal diseases. Annu. Rev. Phytopathol. 2014, 52, 45–68. [Google Scholar] [CrossRef]
- Hibbett, D.S.; Binder, M.; Bischoff, J.F.; Blackwell, M.; Cannon, P.F.; Eriksson, O.E.; Huhndorf, S.; James, T.; Kirk, P.M.; Lücking, R. A higher-level phylogenetic classification of the Fungi. Mycol. Res. 2007, 111, 509–547. [Google Scholar] [CrossRef] [PubMed]
- Wong, J.H.; Ng, T.B.; Chan, H.H.L.; Liu, Q.; Man, G.C.W.; Zhang, C.Z.; Guan, S.; Ng, C.C.W.; Fang, E.F.; Wang, H. Biotechnology, Mushroom extracts and compounds with suppressive action on breast cancer: Evidence from studies using cultured cancer cells, tumor-bearing animals, and clinical trials. Appl. Microbiol. Biotechnol. 2020, 104, 4675–4703. [Google Scholar] [CrossRef]
- Ruán-Soto, F.; Garibay-Orijel, R.; Cifuentes, J. Process and dynamics of traditional selling wild edible mushrooms in tropical Mexico. J. Ethnobiol. Ethnomed. 2006, 2, 3. [Google Scholar] [CrossRef]
- Koltin, Y.; Berick, R.; Stamberg, J.; Ben-Shaul, Y. Virus-like particles and cytoplasmic inheritance of plaques in a higher fungus. Nat. New Biol. 1973, 241, 108–109. [Google Scholar] [CrossRef]
- Khalifa, M.E.; MacDiarmid, R.M. A novel totivirus naturally occurring in two different fungal genera. Front. Microbiol. 2019, 10, 2318. [Google Scholar] [CrossRef] [PubMed]
- Deng, F.; Xu, R.; Boland, G.J. Hypovirulence-associated double-stranded RNA from Sclerotinia homoeocarpa is conspecific with Ophiostoma novo-ulmi mitovirus 3a-Ld. Phytopathology 2003, 93, 1407–1414. [Google Scholar] [CrossRef] [PubMed]
- Wu, M.; Zhang, L.; Li, G.; Jiang, D.; Ghabrial, S.A. Genome characterization of a debilitation-associated mitovirus infecting the phytopathogenic fungus Botrytis cinerea. Virology 2010, 406, 117–126. [Google Scholar] [CrossRef] [PubMed]
- Jia, J.; Fu, Y.; Jiang, D.; Mu, F.; Cheng, J.; Lin, Y.; Li, B.; Marzano, S.-Y.L.; Xie, J. Interannual dynamics, diversity and evolution of the virome in Sclerotinia sclerotiorum from a single crop field. Virus Evol. 2021, 7, veab032. [Google Scholar] [CrossRef]
- Mu, F.; Xie, J.; Cheng, S.; You, M.; Barbetti, M.; Jia, J.; Wang, Q.; Cheng, J.; Fu, Y.; Chen, T. Virome characterization of a collection of Sclerotinia sclerotiorum from Australia. Front. Microbiol. 2017, 8, 2540. [Google Scholar]
- Ruiz-Padilla, A.; Rodríguez-Romero, J.; Gómez-Cid, I.; Pacifico, D.; Ayllón, M.A. Novel mycoviruses discovered in the mycovirome of a necrotrophic fungus. mBio 2021, 12, 10–1128. [Google Scholar] [CrossRef]
- Deng, Y.; Zhou, K.; Wu, M.; Zhang, J.; Yang, L.; Chen, W.; Li, G. Viral cross-class transmission results in disease of a phytopathogenic fungus. ISME J. 2022, 16, 2763–2774. [Google Scholar] [CrossRef]
- Kanematsu, S.; Sasaki, A.; Onoue, M.; Oikawa, Y.; Ito, T. Extending the fungal host range of a partitivirus and a mycoreovirus from Rosellinia necatrix by inoculation of protoplasts with virus particles. Phytopathology 2010, 100, 922–930. [Google Scholar] [CrossRef]
- Vainio, E.J.; Jurvansuu, J.; Hyder, R.; Kashif, M.; Piri, T.; Tuomivirta, T.; Poimala, A.; Xu, P.; Mäkelä, S.; Nitisa, D.; et al. Heterobasidion Partitivirus 13 Mediates Severe Growth Debilitation and Major Alterations in the Gene Expression of a Fungal Forest Pathogen. J. Virol. 2018, 92, e01744-17. [Google Scholar] [CrossRef]
- Xiao, X.; Cheng, J.; Tang, J.; Fu, Y.; Jiang, D.; Baker, T.S.; Ghabrial, S.A.; Xie, J.; Simon, A. A novel partitivirus that confers hypovirulence on plant pathogenic fungi. J. Virol. 2014, 88, 10120–10133. [Google Scholar] [CrossRef]
- Gautam, A.K.; Verma, R.K.; Avasthi, S.; Sushma; Bohra, Y.; Devadatha, B.; Niranjan, M.; Suwannarach, N. Current insight into traditional and modern methods in fungal diversity estimates. J. Fungi 2022, 8, 226. [Google Scholar] [CrossRef] [PubMed]
- Zhang, H.; Xie, J.; Fu, Y.; Cheng, J.; Qu, Z.; Zhao, Z.; Cheng, S.; Chen, T.; Li, B.; Wang, Q.; et al. A 2-kb mycovirus converts a pathogenic fungus into a beneficial endophyte for brassica protection and yield enhancement. Mol. Plant 2020, 13, 1420–1433. [Google Scholar] [CrossRef] [PubMed]
- Griffith, G.W.; Easton, G.L.; Detheridge, A.; Roderick, K.; Edwards, A.; Worgan, H.J.; Nicholson, J.; Perkins, W.T. Copper deficiency in potato dextrose agar causes reduced pigmentation in cultures of various fungi. FEMS Microbiol. Lett. 2007, 276, 165–171. [Google Scholar] [CrossRef]
- Nguyen, L.-T.; Schmidt, H.A.; Von Haeseler, A.; Minh, B.Q. IQ-TREE: A fast and effective stochastic algorithm for estimating maximum-likelihood phylogenies. Mol. Biol. Evol. 2015, 32, 268–274. [Google Scholar] [CrossRef] [PubMed]
- Kakhki, M.P. TRIzol-based RNA extraction: A reliable method for gene expression studies. J. Sci. 2014, 25, 13–17. [Google Scholar]
- Liu, L.; Xie, J.; Cheng, J.; Fu, Y.; Li, G.; Yi, X.; Jiang, D. Fungal negative-stranded RNA virus that is related to bornaviruses and nyaviruses. Proc. Natl. Acad. Sci. USA 2014, 111, 12205–12210. [Google Scholar] [CrossRef]
- Marzano, S.-Y.L.; Nelson, B.D.; Ajayi-Oyetunde, O.; Bradley, C.A.; Hughes, T.J.; Hartman, G.L.; Eastburn, D.M.; Domier, L.L. Identification of diverse mycoviruses through metatranscriptomics characterization of the viromes of five major fungal plant pathogens. J. Virol. 2016, 90, 6846–6863. [Google Scholar] [CrossRef]
- Potgieter, A.C.; Page, N.A.; Liebenberg, J.; Wright, I.M.; Landt, O.; van Dijk, A.A. Improved strategies for sequence-independent amplification and sequencing of viral double-stranded RNA genomes. J. Gen. Virol. 2009, 90, 1423–1432. [Google Scholar] [CrossRef]
- Chen, B.; Choi, G.H.; Nuss, D.L. Attenuation of fungal virulence by synthetic infectious hypovirus transcripts. Science 1994, 264, 1762–1764. [Google Scholar] [CrossRef]
- Nuss, D.L. Hypovirulence: Mycoviruses at the fungal–plant interface. Nat. Rev. Microbiol. 2005, 3, 632–642. [Google Scholar] [CrossRef]
- Hao, F.; Ding, T.; Wu, M.; Zhang, J.; Yang, L.; Chen, W.; Li, G. Two Novel Hypovirulence-associated mycoviruses in the phytopathogenic fungus Botrytis cinerea: Molecular characterization and suppression of infection cushion formation. Viruses 2018, 10, 254. [Google Scholar] [CrossRef] [PubMed]
- Wu, M.D.; Zhang, L.; Li, G.Q.; Jiang, D.H.; Hou, M.S.; Huang, H.C. Hypovirulence and double-stranded RNA in Botrytis cinerea. Phytopathology 2007, 97, 1590–1599. [Google Scholar] [CrossRef] [PubMed]
- Reeslev, A.K.M. Comparison of biomass dry weights and radial growth rates of fungal colonies on media solidified with different gelling compounds. Appl. Environ. Microbiol. 1995, 61, 4236–4239. [Google Scholar] [CrossRef] [PubMed]
- Bu, C.; Zheng, X.; Zhao, X.; Xu, T.; Bai, X.; Jia, Y.; Chen, M.; Hao, L.; Xiao, J.; Zhang, Z.; et al. GenBase: A Nucleotide Sequence Database. Genom. Proteom. Bioinform. 2024, 22, qzae047. [Google Scholar] [CrossRef]
- Bai, X.; Bao, Y.; Bei, S.; Bu, C.; Cao, R.; Cao, Y.; Cen, H.; Chao, J.; Chen, F.; Chen, H.; et al. Database Resources of the National Genomics Data Center, China National Center for Bioinformation in 2024. Nucleic Acids Res. 2024, 52, D18–D32. [Google Scholar]
- De Miccolis Angelini, R.M.; Sardaro, D.; Spadoni, A.; Rotolo, C.; Pollastro, S.; Minafra, A.; Faretra, F. Deep sequencing analysis of the mycovirome in Botrytis cinerea. In XXI Convegno Nazionale Società Italiana di Patologia Vegetale (SIPaV)-Book of Abstracts; Academic Press: Rome, Italy, 2015; p. 47. [Google Scholar]
- Gilmer, D.; Ratti, C.; Consortium, I.R. ICTV virus taxonomy profile: Benyviridae. J. Gen. Virol. 2017, 98, 1571–1572. [Google Scholar] [CrossRef]
- Kiguchi, T.; Saito, M.; Tamada, T. Nucleotide sequence analysis of RNA-5 of five isolates of beet necrotic yellow vein virus and the identity of a deletion mutant. J. Gen. Virol. 1996, 77, 575–580. [Google Scholar] [CrossRef]
- Saito, M.; Kiguchi, T.; Kusume, T.; Tamada, T. Complete nucleotide sequence of the Japanese isolate S of beet necrotic yellow vein virus RNA and comparison with European isolates. Arch. Virol. 1996, 141, 2163–2175. [Google Scholar] [CrossRef]
- Deakin, G.; Dobbs, E.; Bennett, J.M.; Jones, I.M.; Grogan, H.M.; Burton, K.S. Multiple viral infections in Agaricus bisporus-characterisation of 18 unique RNA viruses and 8 ORFans identified by deep sequencing. Sci. Rep. 2017, 7, 2469. [Google Scholar] [CrossRef]
- Magae, Y. Molecular characterization of a novel mycovirus in the cultivated mushroom, Lentinula edodes. Virol. J. 2012, 9, 60. [Google Scholar] [CrossRef]
- Shi, R.; Mo, X.; Chen, Z.; Chen, W.; Yu, S.; Liu, H.; Li, Y.; Dai, L.; Li, Y. Molecular characterization of a novel mycovirus from binucleate Rhizoctonia AG-A strain A46. Arch. Virol. 2024, 169, 31. [Google Scholar] [CrossRef] [PubMed]
- De Miccolis Angelini, R.M.; Raguseo, C.; Rotolo, C.; Gerin, D.; Faretra, F.; Pollastro, S. The mycovirome in a worldwide collection of the brown rot fungus Monilinia fructicola. J. Fungi 2022, 8, 481. [Google Scholar] [CrossRef]
- Abdoulaye, A.H.; Foda, M.F.; Kotta-Loizou, I. Viruses infecting the plant pathogenic fungus Rhizoctonia solani. Viruses 2019, 11, 1113. [Google Scholar] [CrossRef] [PubMed]
- Wolf, Y.I.; Kazlauskas, D.; Iranzo, J.; Lucía-Sanz, A.; Kuhn, J.H.; Krupovic, M.; Dolja, V.V.; Koonin, E.V. Origins and evolution of the global RNA virome. mBio 2018, 9, 10–1128. [Google Scholar] [CrossRef]
- Stielow, J.B.; Bratek, Z.; Klenk, H.-P.; Winter, S.; Menzel, W. A novel mitovirus from the hypogeous ectomycorrhizal fungus Tuber excavatum. Arch. Virol. 2012, 157, 787–790. [Google Scholar] [CrossRef] [PubMed]
- Martínez-Álvarez, P.; Vainio, E.J.; Botella, L.; Hantula, J.; Diez, J.J. Three mitovirus strains infecting a single isolate of Fusarium circinatum are the first putative members of the family Narnaviridae detected in a fungus of the genus Fusarium. Arch. Virol. 2014, 159, 2153–2155. [Google Scholar] [CrossRef]
- Polashock, J.J.; Hillman, B.I. A small mitochondrial double-stranded (ds) RNA element associated with a hypovirulent strain of the chestnut blight fungus and ancestrally related to yeast cytoplasmic T and W dsRNAs. Proc. Natl. Acad. Sci. USA 1994, 91, 8680–8684. [Google Scholar] [CrossRef]
- Nibert, M.L.; Vong, M.; Fugate, K.K.; Debat, H.J. Evidence for contemporary plant mitoviruses. J. Virol. 2018, 518, 14–24. [Google Scholar] [CrossRef]
- Sun, K.; Lu, H.; Fan, F.; Zhang, P.; Liu, G.; Yu, X. Occurrence of Chenopodium quinoa mitovirus 1 in Chenopodium quinoa in China. Plant Dis. 2021, 105, 715. [Google Scholar] [CrossRef]
- Miotti, N.; Sukhikh, N.; Laboureau, N.; Casati, P.; Pooggin, M.M. Cannabis virome reconstruction and antiviral RNAi characterization through small RNA sequencing. Plants 2023, 12, 3925. [Google Scholar] [CrossRef]
- Vong, M.; Manny, A.R.; Smith, K.L.; Gao, W.; Nibert, M.L. Beta vulgaris mitovirus 1 in diverse cultivars of beet and chard. Virus Res. 2019, 265, 80–87. [Google Scholar] [CrossRef] [PubMed]
- Wang, Q.; Zou, Q.; Dai, Z.; Hong, N.; Wang, G.; Wang, L. Four novel mycoviruses from the hypovirulent Botrytis cinerea SZ-2-3y isolate from Paris polyphylla: Molecular characterisation and mitoviral sequence transboundary entry into plants. Viruses 2022, 14, 151. [Google Scholar] [CrossRef]
- Khalifa, M.E.; Dessoky, E.S.; Sadik, A.S. Molecular characterization and blological control potential of an egyptian isolate of Sclerotinia sclerotiorum mitovirus. J. Anim. Plant Sci. 2022, 32, 1101–1109. [Google Scholar]
- Xie, J.; Ghabrial, S.A. Molecular characterizations of two mitoviruses co-infecting a hyovirulent isolate of the plant pathogenic fungus Sclerotinia sclerotiorum. J. Virol. 2012, 428, 77–85. [Google Scholar] [CrossRef] [PubMed]
- Khalifa, M.E.; Pearson, M.N. Molecular characterization of three mitoviruses co-infecting a hypovirulent isolate of Sclerotinia sclerotiorum fungus. J. Virol. 2013, 441, 22–30. [Google Scholar] [CrossRef] [PubMed]
- Khalifa, M.E.; Pearson, M.N. Molecular characterisation of novel mitoviruses associated with Sclerotinia sclerotiorum. Arch. Virol. 2014, 159, 3157–3160. [Google Scholar] [CrossRef]
- Li, P.; Bhattacharjee, P.; Wang, S.; Zhang, L.; Ahmed, I.; Guo, L. Mycoviruses in Fusarium species: An update. Front. Cell. Infect. Microbiol. 2019, 9, 257. [Google Scholar] [CrossRef]
- Jacquat, A.G.; Theumer, M.G.; Cañizares, M.C.; Debat, H.J.; Iglesias, J.; García Pedrajas, M.D.; Dambolena, J.S. A survey of mycoviral infection in Fusarium spp. isolated from maize and sorghum in argentina identifies the first mycovirus from Fusarium verticillioides. Viruses 2020, 12, 1161. [Google Scholar] [CrossRef]
- Huang, H.; Hua, X.; Pang, X.; Zhang, Z.; Ren, J.; Cheng, J.; Fu, Y.; Xiao, X.; Lin, Y.; Chen, T. Discovery and characterization of putative glycoprotein-encoding mycoviruses in the Bunyavirales. J. Virol. 2023, 97, e01381-22. [Google Scholar] [CrossRef]
- Torres-Trenas, A.; Pérez-Artés, E. Characterization and incidence of the first member of the genus Mitovirus identified in the phytopathogenic species Fusarium oxysporum. Viruses 2020, 12, 279. [Google Scholar] [CrossRef]
- Komatsu, K.; Katayama, Y.; Omatsu, T.; Mizutani, T.; Fukuhara, T.; Kodama, M.; Arie, T.; Teraoka, T.; Moriyama, H. Genome sequence of a novel mitovirus identified in the phytopathogenic fungus Alternaria arborescens. Arch. Virol. 2016, 161, 2627–2631. [Google Scholar] [CrossRef] [PubMed]
- Chen, Y.; Shang, H.H.; Yang, H.Q.; Da Gao, B.; Zhong, J. A mitovirus isolated from the phytopathogenic fungus Alternaria brassicicola. Arch. Virol. 2017, 162, 2869–2874. [Google Scholar] [CrossRef] [PubMed]
- Nerva, L.; Turina, M.; Zanzotto, A.; Gardiman, M.; Gaiotti, F.; Gambino, G.; Chitarra, W. Isolation, molecular characterization and virome analysis of culturable wood fungal endophytes in esca symptomatic and asymptomatic grapevine plants. Environ. Microbiol. 2019, 21, 2886–2904. [Google Scholar] [CrossRef] [PubMed]
- Tuomivirta, T.T.; Hantula, J. Gremmeniella abietina mitochondrial RNA virus S1 is phylogenetically related to the members of the genus Mitovirus. Arch. Virol. 2003, 148, 2429–2436. [Google Scholar] [CrossRef] [PubMed]
- Botella, L.; Tuomivirta, T.T.; Vervuurt, S.; Diez, J.J.; Hantula, J. Occurrence of two different species of mitoviruses in the European race of Gremmeniella abietina var. abietina, both hosted by the genetically unique Spanish population. Fungal Biol. 2012, 116, 872–882. [Google Scholar] [CrossRef]
- Doherty, M.; Coutts, R.H.; Brasier, C.M.; Buck, K.W. Sequence of RNA-dependent RNA polymerase genes provides evidence for three more distinct mitoviruses in Ophiostoma novo-ulmi isolate Ld. Virus Genes 2006, 33, 41–44. [Google Scholar] [CrossRef]
- Hong, Y.; Dover, S.L.; Cole, T.E.; Brasier, C.M.; Buck, K.W. Multiple mitochondrial viruses in an isolate of the Dutch elm disease fungus Ophiostoma novo-Ulmi. Virology 1999, 258, 118–127. [Google Scholar] [CrossRef]
- Liu, H.; Liu, M.; Zhu, H.; Zhong, J.; Liao, X.; Zhou, Q. Molecular characterization of a novel mitovirus from the plant-pathogenic fungus Botryosphaeria dothidea. Arch. Virol. 2021, 166, 633–637. [Google Scholar] [CrossRef]
- Wang, H.; Liu, H.; Lu, X.; Wang, Y.; Zhou, Q. A novel mitovirus isolated from the phytopathogenic fungus Botryosphaeria dothidea. Arch. Virol. 2021, 166, 1507–1511. [Google Scholar] [CrossRef]
- Chen, H.; Jin, L.; Jiang, X.; Yu, Z.; Duns, G.J.; Shao, R.; Xu, W.; Chen, J. A novel mitovirus from Buergenerula spartinae infecting the invasive species Spartina alterniflora. Virol. Sin. 2014, 29, 257–260. [Google Scholar] [CrossRef]
- Vainio, E.J.; Jurvansuu, J.; Streng, J.; Rajamäki, M.-L.; Hantula, J.; Valkonen, J.P. Diagnosis and discovery of fungal viruses using deep sequencing of small RNAs. J. Gen. Virol. 2015, 96, 714–725. [Google Scholar] [CrossRef] [PubMed]
- Wu, S.; Cheng, J.; Fu, Y.; Chen, T.; Jiang, D.; Ghabrial, S.A.; Xie, J. Virus-mediated suppression of host non-self recognition facilitates horizontal transmission of heterologous viruses. PLoS Pathog. 2017, 13, e1006234. [Google Scholar] [CrossRef]
- Hai, D.; Li, J.; Jiang, D.; Cheng, J.; Fu, Y.; Xiao, X.; Yin, H.; Lin, Y.; Chen, T.; Li, B.; et al. Plants interfere with non-self recognition of a phytopathogenic fungus via proline accumulation to facilitate mycovirus transmission. Nat. Commun. 2024, 15, 4748. [Google Scholar] [CrossRef]
- Liu, S.; Xie, J.; Cheng, J.; Li, B.; Chen, T.; Fu, Y.; Li, G.; Wang, M.; Jin, H.; Wan, H. Fungal DNA virus infects a mycophagous insect and utilizes it as a transmission vector. Proc. Natl. Acad. Sci. USA 2016, 113, 12803–12808. [Google Scholar] [CrossRef]
- Wu, M.; Deng, Y.; Zhou, Z.; He, G.; Chen, W.; Li, G. Characterization of three mycoviruses co-infecting the plant pathogenic fungus Sclerotinia nivalis. Virus Res. 2016, 223, 28–38. [Google Scholar] [CrossRef] [PubMed]
- Wu, M.; Jin, F.; Zhang, J.; Yang, L.; Jiang, D.; Li, G. Characterization of a novel bipartite double-stranded RNA mycovirus conferring hypovirulence in the phytopathogenic fungus Botrytis porri. J. Virol. 2012, 86, 6605–6619. [Google Scholar] [CrossRef] [PubMed]
- Botella, L.; Hantula, J. Description, Distribution, and relevance of viruses of the forest pathogen Gremmeniella abietina. Viruses 2018, 10, 654. [Google Scholar] [CrossRef]
- Cornejo, C.; Hisano, S.; Bragança, H.; Suzuki, N.; Rigling, D. A new double-stranded RNA mycovirus in Cryphonectria naterciae is able to cross the species barrier and is deleterious to a new host. J. Fungi 2021, 7, 861. [Google Scholar] [CrossRef]
- Cai, Q.; Qiao, L.; Wang, M.; He, B.; Lin, F.-M.; Palmquist, J.; Huang, S.-D.; Jin, H. Plants send small RNAs in extracellular vesicles to fungal pathogen to silence virulence genes. Science 2018, 360, 1126–1129. [Google Scholar] [CrossRef]
- Weiberg, A.; Wang, M.; Lin, F.-M.; Zhao, H.; Zhang, Z.; Kaloshian, I.; Huang, H.-D.; Jin, H. Fungal small RNAs suppress plant immunity by hijacking host RNA interference pathways. Science 2013, 342, 118–123. [Google Scholar] [CrossRef]
- Wang, Q.; Mu, F.; Xie, J.; Cheng, J.; Fu, Y.; Jiang, D. A single ssRNA segment encoding RdRp is sufficient for replication, infection, and transmission of ourmia-like virus in fungi. Front. Microbiol. 2020, 11, 379. [Google Scholar] [CrossRef] [PubMed]

| Hit | Probability (%) | Identities (%) | E-Value | p-Value | Query HMM | Template HMM |
|---|---|---|---|---|---|---|
| Capsid protein [Hepatitis E virus] | 97.8 | 16 | 4.3 × 10−5 | 4.5 × 10−10 | 15–152 (242) | 80–258 (660) |
| Capsid protein [Hepatitis E virus genotype 2] | 97.48 | 17 | 0.0002 | 2 × 10−9 | 13–152 (242) | 78–258 (659) |
| Capsid protein [Hepatitis E virus type 4] | 97.43 | 17 | 0.00034 | 3.5 × 10−9 | 35–152 (242) | 2–148 (504) |
| Capsid protein [Avian hepatitis E virus] | 97.14 | 19 | 0.0011 | 1.2 × 10−8 | 22–152 (242) | 40–203 (606) |
| Capsid readthrough protein [Beet necrotic yellow vein virus] | 93.80 | 17 | 0.011 | 1.2 × 10−7 | 13–214 (242) | 14–174 (690) |
| Ilarvirus coat protein [Prunus necrotic ringspot virus] | 83.72 | 14 | 2.9 | 3 × 10−5 | 1–242 | 1–205 (208) |
Disclaimer/Publisher’s Note: The statements, opinions and data contained in all publications are solely those of the individual author(s) and contributor(s) and not of MDPI and/or the editor(s). MDPI and/or the editor(s) disclaim responsibility for any injury to people or property resulting from any ideas, methods, instructions or products referred to in the content. |
© 2024 by the authors. Licensee MDPI, Basel, Switzerland. This article is an open access article distributed under the terms and conditions of the Creative Commons Attribution (CC BY) license (https://creativecommons.org/licenses/by/4.0/).
Share and Cite
Duan, J.; Zhang, A.; Fu, Y.; Lin, Y.; Xie, J.; Cheng, J.; Chen, T.; Li, B.; Yu, X.; Lyu, X.; et al. A Mycovirus Representing a Novel Lineage and a Mitovirus of Botrytis cinerea Co-Infect a Basidiomycetous Fungus, Schizophyllum commune. Viruses 2024, 16, 1767. https://doi.org/10.3390/v16111767
Duan J, Zhang A, Fu Y, Lin Y, Xie J, Cheng J, Chen T, Li B, Yu X, Lyu X, et al. A Mycovirus Representing a Novel Lineage and a Mitovirus of Botrytis cinerea Co-Infect a Basidiomycetous Fungus, Schizophyllum commune. Viruses. 2024; 16(11):1767. https://doi.org/10.3390/v16111767
Chicago/Turabian StyleDuan, Jie, Anmeng Zhang, Yanping Fu, Yang Lin, Jiatao Xie, Jiasen Cheng, Tao Chen, Bo Li, Xiao Yu, Xueliang Lyu, and et al. 2024. "A Mycovirus Representing a Novel Lineage and a Mitovirus of Botrytis cinerea Co-Infect a Basidiomycetous Fungus, Schizophyllum commune" Viruses 16, no. 11: 1767. https://doi.org/10.3390/v16111767
APA StyleDuan, J., Zhang, A., Fu, Y., Lin, Y., Xie, J., Cheng, J., Chen, T., Li, B., Yu, X., Lyu, X., & Jiang, D. (2024). A Mycovirus Representing a Novel Lineage and a Mitovirus of Botrytis cinerea Co-Infect a Basidiomycetous Fungus, Schizophyllum commune. Viruses, 16(11), 1767. https://doi.org/10.3390/v16111767

